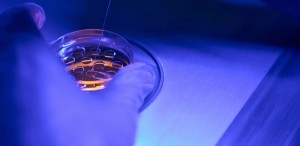

A inteligência artificial (IA) vem transformando, cada vez mais, a medicina reprodutiva. Se, no início, ela era vista apenas como um recurso de análise de dados, hoje já está presente em etapas decisivas da fertilização in vitro (FIV), desde a avaliação da qualidade dos óvulos até a escolha do embrião com maior potencial de implantação. Nos últimos anos, avanços importantes também vêm sendo observados na infertilidade masculina, um campo historicamente menos explorado.
“O uso de algoritmos de aprendizado em reprodução assistida não é apenas um detalhe tecnológico, mas um divisor de águas”, afirma o ginecologista e obstetra especializado em reprodução humana Vamberto Maia Filho. “A IA consegue identificar padrões invisíveis ao olho humano e auxiliar em decisões que impactam diretamente o bem-estar físico e emocional das pacientes”, resume o médico.
IA e personalização da jornada reprodutiva
O grande diferencial da IA, de acordo com o especialista, é a capacidade de transformar dados clínicos em recomendações individualizadas. Segundo a Associação Brasileira de Reprodução Assistida (SBRA), ao cruzar informações de ciclos anteriores, exames de imagem e parâmetros laboratoriais, os algoritmos conseguem prever a resposta de cada paciente a medicamentos, reduzir doses desnecessárias de hormônio e indicar o momento mais seguro para a coleta de óvulos.
Para Vamberto, essa personalização não significa apenas melhores taxas de gravidez, mas também menor desgaste físico e emocional: “A cada ciclo evitado, diminuem os efeitos colaterais, a ansiedade e o impacto psicológico de não engravidar. É um ganho invisível, mas imenso, para a saúde ginecológica”, comemora.
Maior atenção para a infertilidade masculina
A IA também abre novas perspectivas também para os homens, pensando na questão da fertilidade. Em casos de baixa contagem ou alteração na forma dos espermatozoides, sistemas inteligentes já conseguem analisar motilidade e morfologia de milhares de células em segundos, indicando aquelas com maior chance de fertilizar o óvulo.
Esse avanço traz impacto direto na equidade dos tratamentos, ressalta o especialista: “Quando a IA ajuda a selecionar espermatozoides mais saudáveis, ela reduz a necessidade de procedimentos invasivos nas mulheres. É uma mudança de paradigma, porque reconhece que a infertilidade é uma condição do casal, e não apenas da paciente”, resume.
Ética, confiança e bem-estar no centro da inovação
Embora a tecnologia avance rapidamente, a supervisão médica continua indispensável. Para o Vamberto, a chave está no equilíbrio: “A IA traz dados, mas quem traduz esses dados em cuidado é o médico. Não se trata de substituir a decisão clínica, e sim de somar precisão à sensibilidade humana”, acrescenta.
Além disso, a IA tem ampliado a transparência dos tratamentos. Com sistemas de monitoramento em tempo real, pacientes podem acompanhar a evolução de embriões em incubadoras time-lapse e receber relatórios explicativos. Esse envolvimento aumenta a confiança, a sensação de pertencimento ao processo e a segurança emocional durante a jornada da FIV.
Apesar das promessas, a tecnologia ainda exige estudos robustos para comprovar resultados em larga escala. No entanto, a perspectiva é clara: quanto mais os algoritmos aprenderem com os ciclos realizados, mais precisas se tornarão as recomendações.
“Estamos entrando na era da FIV do futuro, em que cada tratamento poderá ser moldado de acordo com a biologia e as necessidades de cada casa. O que mais me entusiasma é que, no fim, a inteligência artificial não vai apenas aumentar taxas de sucesso. Ela vai devolver qualidade de vida, reduzir o sofrimento e tornar a medicina reprodutiva mais humana. Os médicos jamais serão substituídos pela IA, mas os que não usarem usar IA serão sim substituídos!”, conclui o médico.
Matéra publicada na Medicina S/A

